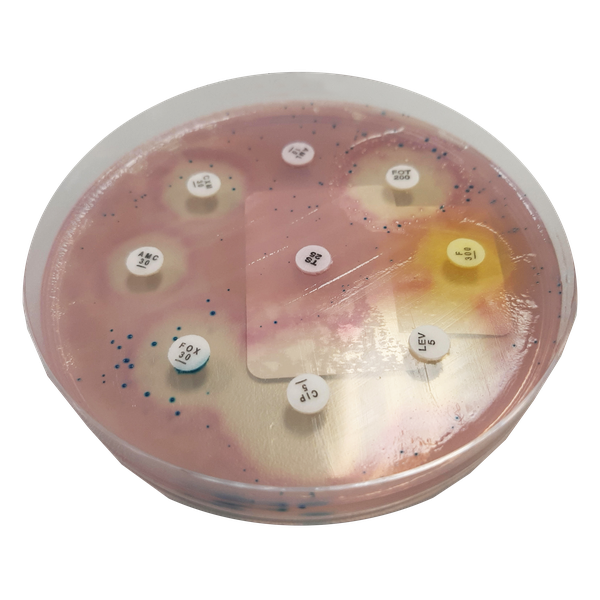
CHROMagar™ MH Orientation

Hình thái khuẩn lạc

E. coli hồng đậm đến đỏ
Klebsiella, Enterobacter, Citrobacter
xanh kim loại
Hiệu năng
Hiệu năng
CHROMagar™ MH Orientation là môi trường thạch Mueller Hinton chromogen. Sản phẩm này được phát triển nhằm rút ngắn thời gian thu được kết quả bằng cách kết hợp sự phân biệt chromogen của các loài trong mẫu và xét nghiệm kháng sinh đồ. Công cụ này cho phép có kết quả trong cùng ngày ở cả hai lĩnh vực, nhận diện và kháng thuốc, trực tiếp từ nuôi cấy sơ cấp, khác với quy trình truyền thống mất tới 48 giờ.
Một đánh giá đã được thực hiện bởi AB Biodisk vào năm 2008, so sánh hiệu năng của CHROMagar™ MH Orientation với công thức Mueller-Hinton truyền thống1. Nghiên cứu này, thực hiện với hơn 20 chất kháng khuẩn cổ điển, kết luận rằng việc sử dụng môi trường này với dải E-test có thể cung cấp kết quả trong ngày.
CHROMagar™ MH Orientation đã được sử dụng chủ yếu trong hai ứng dụng, nhưng chắc chắn nó còn hữu ích trong nhiều trường hợp khác. Ứng dụng đầu tiên là trên các mẫu từ bệnh nhân ICU với viêm phổi liên quan đến máy thở (VAP), một trong những nhiễm khuẩn bệnh viện ICU phổ biến với tỷ lệ mắc và tử vong cao. Việc rút ngắn thời gian tối ưu hóa trị liệu theo kinh nghiệm dẫn đến kết quả tốt hơn. Như được phát biểu bởi nhóm nghiên cứu Tây Ban Nha, dẫn đầu trong quy trình này2, cấy mẫu hô hấp trực tiếp lên CHROMagar™ MH Orientation là “một quy trình nhanh cho xét nghiệm kháng sinh đồ (...) quan trọng để sửa đổi chế độ trị liệu”.
Ứng dụng thứ hai là các nhiễm trùng đường tiết niệu (UTI) thông thường mà bác sĩ thường kê đơn trị liệu theo kinh nghiệm. Mẫu nước tiểu với số lượng nhiễm trùng điển hình từ 103-105 cfu/mL có thể được rải trực tiếp lên đĩa này. Mẫu đa vi khuẩn cũng như mẫu nhiễm đơn vi khuẩn có thể dễ dàng được điều tra bằng phương pháp này. Cũng như trong trường hợp VAP, kết quả nhận diện và kháng thuốc trong cùng ngày có thể xác nhận liệu pháp theo kinh nghiệm, hoặc giúp quyết định thay đổi.
Tài liệu tham khảo: 1 Engelhardt A. et al, Rapid E-test® MIC Testing Using CHROMagar™ And Mueller Hinton Agar For Gram Positive And Gram Negative Aerobes - ECCMID 2008 2 E. Cercenado et al, Evaluation of direct E-test on lower respiratory tract samples using a chromogenic agar medium: a rapid procedure for antimicrobial susceptibility testing - ECCMID 2009
1. 2 trong 1: Cho phép nhận diện chromogen và kháng sinh đồ trên cùng đĩa.
2. Kết quả nhanh chóng: Đối với nhiều vi sinh vật/kháng sinh, kết quả có thể đọc ngay sau ủ qua đêm.
3. Dễ đọc đĩa: Nhờ các phản ứng chromogen, đường kính và/hoặc vùng ức chế được xác định rõ ràng.
Thành phần

Tài liệu kỹ thuật
Công bố khoa học
2023
Utilidad del CHROMagarTM MH orientation para la identificación y antibiograma directo de gram negativos en orinas con bacteriuria significativa
📄 Publication2021
Direct disk diffusion test during bacteremia: evaluation of antibiotic susceptibility results
📄 Publication2018
Screening prior to prostatic biopsy - a disk diffusion based method for detection of fluoroquinolone resistant Enterobacteriaceae in rectal swabs
📄 Publication2018
Addition of disk diffusion based screening on chromogenic Mueller-Hinton agar adds value to traditional cephalosporin based screening for multiresistant Gram-negative bacteria
📄 Publication2011
Evaluation of Rapid E Test MIC Testing Using CHROMagar on Lower Respiratory Tract Samples; Collected From ICU From Patients With Suspected Ventilator Associated Pneumonia Category: Lesson In Microbiology & Infection Control
📄 Publication2009
Evaluation of direct E-test on lower respiratory tract samples using a chromogenic agar medium: a rapid procedure for antimicrobial susceptibility testing
📄 Publication20098
Rapid Etest® MIC Testing Using ChRoMagarTM And Mueller hinton Agar For Gram Positive And Gram Negative Aerobes
📄 Publication

Xem thêm